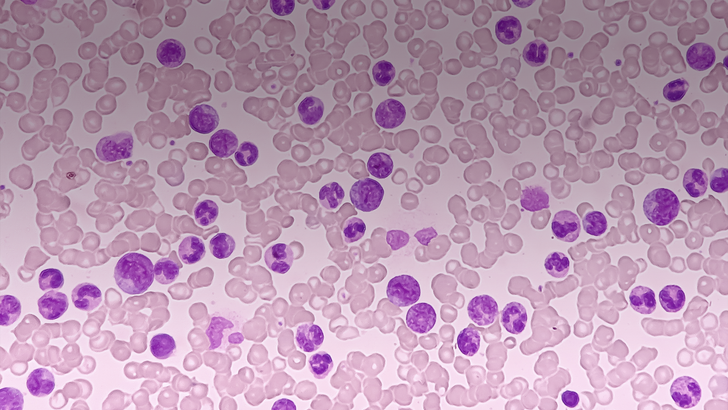
ReachMD Healthcare Image

Although the first-generation tyrosine kinase inhibitors (TKIs) revolutionized the treatment of Ph+ CML-CP, the rate of resistance to these agents is high, and many patients require further treatment with second- and third-line therapy. The development of newer drugs with unique mechanisms that can overcome these resistance phenotypes offers new treatment strategies that can maintain response rates. This activity reviews the current treatment options for newly diagnosed disease and the importance of integrating patient preference when planning therapeutic regimens.
Chairperson's Perspective: Novel Treatments for Newly Diagnosed Ph+ CML-CP: Striking the Balance of Treatment With Patient Goals and QoL
Transcript
Chairperson's Perspective: Novel Treatments for Newly Diagnosed Ph+ CML-CP: Striking the Balance of Treatment With Patient Goals and QoL
closeTranscript
Chairperson's Perspective: Novel Treatments for Newly Diagnosed Ph+ CML-CP: Striking the Balance of Treatment With Patient Goals and QoL
closeTranscript
Chairperson's Perspective: Novel Treatments for Newly Diagnosed Ph+ CML-CP: Striking the Balance of Treatment With Patient Goals and QoL
closeAnnouncer:
Welcome to CME on ReachMD. This activity, titled “Chairperson's Perspective: Novel Treatments for Newly Diagnosed Ph+ CML-CP: Striking the Balance of Treatment With Patient Goals and QoL” is provided by AXIS Medical Education.
Prior to beginning the activity, please be sure to review the faculty and commercial support disclosure statements as well as the learning objectives.
Dr. Cortes:
Hello. My name is Jorge Cortes, and I'm going to be talking today about some of the novel treatments for the newly diagnosed patients with chronic myeloid leukemia in the chronic phase, and how we balance the treatment goals and the quality of life in this process.
Let's start first by an overview of the current treatments and the kind of interventions that we can do for the management of our patients. We today have seven different treatment options for patients with chronic myeloid leukemia. One of them, omacetaxine, is not a tyrosine kinase inhibitor; it's a drug that is intravenous, it's a protein synthesis inhibitor. We have six tyrosine kinase inhibitors. Of them, one, asciminib, is a STAMP inhibitor. That means it inhibits the myristoyl pocket of the ABL kinase. It is the only one that has this mechanism of action. All the other inhibitors are competitive ATP inhibitors. They have different properties. Some of them are indicated for different lines of therapy, imatinib only first line. The second generations, first, second, and third line and beyond, whereas ponatinib is only for second and third line and beyond. And asciminib, very recently got approval for all lines of therapy as well.
When we have a new patient usually a mental algorithm that I follow is as follows: first I have to decide, am I going to give them imatinib, or am I going to give them a second-generation TKI? Now, with the very recent approval of asciminib, that even becomes a third choice that I need to decide. If I'm going to give a second-generation TKI, then I also have to decide which one of the three different drugs am I going to use.
To kind of solve this puzzle, so usually what we want to see is the balance of the different elements that come into this decision. For example, what is the efficacy of the drug? What are the expected side effects of the drug? What are the comorbidities of my patients? What is the schedule of administration? What do I know about all of these drugs? The Sokal risk classification of my patient, and so on? With that, then we have to look very importantly at the patient goals. What is the goals that the patients are aiming for? Just having a longer survival? Having fewer side effects? Aiming for treatment-free remission? Frequently, it's a combination of these, and therefore we need to see what gives me the best balance to achieve those goals.
We all know that all of these drugs are very good. All the ones that are available for frontline therapy are very good. Imatinib is a good drug. Second-generation tyrosine kinase inhibitors are also very good drugs. We know that in randomized studies, however, they provided some benefits over imatinib. They had better probability of achieving a response. The responses happened earlier. The responses were deeper, more deep molecular responses. There were fewer transformations to accelerated and blast phase. Now, still many patients ended up having this continuing therapy.
So as good as all these results have been with these studies, we know that there have been some challenges that still remain. About 40% of patients end up having to change therapy by 5 years. Only about 60% achieve deep molecular responses. And only about 50% are eligible for treatment discontinuation, and many of those who discontinue then have to resume therapy. There's also the risks. Arterial occlusive events are common to most of these drugs, particularly the second generation. There are a lot of low-grade but chronic adverse events that limit the quality of life of our patients. So better treatment options are therefore important.
Well, recently, asciminib has shown in a randomized study that in terms of efficacy, it provides a better probability of response. The primary endpoint of this study was major molecule response at about 48 weeks. And compared to any of the tyrosine kinase inhibitors that is approved for frontline therapy, it showed a benefit and improved probability of response, and also for other responses, early molecular response, deep molecular responses. Another co-primary endpoint was the comparison versus specifically imatinib. And here we see an even larger benefit of asciminib compared to imatinib.
And although not a primary endpoint and not powered for this outcome, it also showed a benefit compared to the second-generation TKIs, not only for major molecular response at 48 weeks, but also these other efficacy endpoints.
Importantly, the toxicity profile seemed to be equal or actually better in most of these adverse events. Here you see all the non-hematologic adverse events that all occurred at the same frequency or less, with asciminib. And the hematologic toxicities that also occurred at the same frequency or less than what we see with second-generation TKIs, showing that asciminib is a very valuable addition to our frontline armamentarium.
Let us talk now about the treatment goals in chronic phase CML. Well, as the treatment has evolved over the years from hydroxyurea to interferon and then to TKIs, and we have had better tools to assess the response of our patients, the goals of therapy have evolved from just symptomatic control, then survival, and more and more towards event-free survival and nowadays treatment-free remission. And for the patient from just wanting to live longer, they now want to live better, emphasizing the quality of life and eventually being cured.
So to be able to follow this path, we want to do proper monitoring of our patients. And these are the recommendations by the ELN and the NCCN, very similar. At diagnosis, we want to do a bone marrow aspiration with cytogenetics, FISH, PCR. And very importantly to monitor the patients with PCR every 3 months. And once the patient achieves a stable molecular response, you can continue every 3 to every 6 months the monitoring. Very important to do this regularly to assess the response. If there is failure, we do a assessment of mutations to see if this can guide our further treatments.
The goals of response have evolved earlier with interferon. We focused on cytogenetic responses with the ultimate goal was to achieve a complete cytogenetic response. Now we aim for deeper responses, and we go for major molecular response. But importantly, for the deeper molecular responses defined as MR4, meaning BCR-ABL of 0.01% or less, or even better, MR4.5, 0.0032% or less. And those are the goals that we want to achieve over the course of therapy.
What do we get with these responses? Well, complete cytogenetic response is very important because it correlates with improved survival. Major molecular response, once the patient achieves a complete cytogenetic response, correlates with a lower probability of a relapse, essentially a better probability of event-free survival. But deeper molecular responses are important because they provide the possibility of treatment discontinuation.
But because of these, the NCCN has provided some guidelines as to what is optimal for the patient to achieve to have the signal that the patient is aiming for that deepest response, best possibility of treatment discontinuation. And it's based on the responses at 3 and 6 and 12 months. And they tell us what is optimal, what is green, what is intermediate, what's yellow or orange, and what is not good, which is the red. the ELN has similar guidelines, probably a little bit more ambitious. They define optimal as a little bit deeper than the NCCN. But ultimately following the same kind of approach in both treatment recommendations.
Now, there's this intermediate category that is important. The optimal, of course, we continue therapy. The failure, we recommend change of therapy when possible. But in that warning or suboptimal response or the yellow or orange, there are different possibilities. Usually, it just means that you need to monitor the patient closer. In some instances, you may want to consider change. In many others, you want to continue the same therapy, but with closer monitoring of the patients. And this is emphasized by some recent data from Germany that has shown that patients that at least in the earlier timepoints, 3 and 6 months, that may have a suboptimal response, may still have a similar probability of survival. Therefore, no urgency on changing therapy. When you start getting to 12 months and 24 months, these higher transcript levels do correlate with a poorer outcome.
One category that has been somewhat controversial is these early molecular responses. We know that patients with more than 10% transcripts at 3 months have a lower probability of progression-free survival and a lower probability of overall survival. However, interventions changing therapy, at least from imatinib to in this randomized study, dasatinib, has shown that although you can somewhat improve the probability of major molecular response, you really don't change the probability of progression-free survival and overall survival. So that intervention is not necessarily always indicated, and that's why that possibility of different options that is recommended for these suboptimal responses.
Now, we have to remember that these 3-month responses are not only important for survival and progression-free survival, but these early responders are the ones that have the best probability of achieving a deep molecular response and eventually being eligible for treatment-free remission. That's why we emphasize that early responses, and the more patients that achieve every molecular responses, the better.
So talking about treatment-free remission, we know that we want to achieve a sustained deep molecule response. That's a criteria for treatment discontinuation. And then when you stop therapy, you need to monitor the patients very close. However, the problem is that at best, 50% of the patients, even with a second-generation TKI, are eligible for treatment discontinuation. And of those who discontinued therapy, about half are going to relapse. Again, emphasizing that we still have room for improvement to improve the probability of treatment-free remission.
Finally, let's talk about some strategies for the management of adverse events related to tyrosine kinase inhibitors. We need to remember these are very good drugs, but ultimately it is a balance between the risk and the benefit of the drugs. We want to obtain the outmost benefit with the drug that we use with the minimum risk for the patients, not only of the serious adverse event, but also of those low-grade toxicities that limit the quality of life of the patients.
And this is highlighted by a study that was done by patients for patients, where they asked them: What is your main motivation for stopping treatment? And one of the most important considerations for them is to manage the side effects. They are having side effects that they want to get rid of. We probably cannot call them intolerant, but they’re definitely affecting their quality of life. And also very important is that when we have assessed the severity of the adverse event as defined by a patient and as defined by a physician, the patients are telling us that we are underestimating the significance of the adverse events in their quality of life. So we should not forget this aspect.
Well, we know that all of these drugs are generally safe. They're very similar. And there are different precautions that we need to monitor for all the drugs. They are in the label of each one of these drugs, some of them are common, like myelosuppression, some sort of fluid retention and so on. So it is important to familiarize yourself with what kind of expected adverse events you can see with each one of these drugs.
There are some that are not common that we need to remember. For example, a decline in the renal function. With imatinib, we see that in a significant number of patients, a decline in the glomerular filtration rate. With bosutinib, we see that as well, similar to with imatinib. We don't see that as much with dasatinib or nilotinib. Arterial occlusive events are also very important. There have been meta-analyses that have shown that compared to imatinib, ponatinib, nilotinib, and dasatinib, they all significantly increase the risk of arterial occlusive events. Bosutinib is perhaps the safest of all these second- generation TKIs, but it's still not quite as safe as imatinib. What we know so far with asciminib is that the risk is much lower than what we expect from ponatinib, probably closer to bosutinib, although maybe slightly higher than that.
Based on the known toxicity profile of these drugs, we can select what drug may be more beneficial for a patient, which drug is more likely to be well tolerated. For example, a patient with diabetes, I may not want to use nilotinib as my first choice. If a patient has GI issues, I may not want to use bosutinib. If a patient has lung problems, I may not want to use dasatinib.
Now, fortunately, newer drugs like asciminib have a very good safety profile, as I showed you, and there are very few instances where I would think not to use asciminib as frontline.
I mentioned myelosuppression is a common feature for nearly all of these drugs. We have parameters that when the patients develop grade 3 toxicity, it’s better to hold therapy and then resume when the patient has recovered. It's very important to monitor these. And we have other toxicities that we always need to remember to manage properly to minimize the impact that these toxicities can have on the quality of life of our patients. There have been some guidelines for the management of the cardiovascular risk factors. Very important to assess comorbidities and manage aggressively comorbidities for the patients and use the drugs that may have the lowest risk of arterial occlusive events for patients at very high risk.
And we should not forget that the patient, there may be some cross intolerance between TKI, some adverse events are common to all of them. Myelosuppression, I mentioned. Lipase elevation. So managing doses and trying to avoid those where we can expect more cross intolerance is important.
Ultimately, we need to remember that the patient, we don't just have to treat them with a TKI and monitor the PCR, the patient is an individual that has comorbidities, that has goals, that has a quality of life that we need to preserve. And to do a holistic management of our patient, we need to integrate all of these so that we can do the best for our patients.
Let us talk now about a patient. We have a 72-year-old gentleman diagnosed with CML. He has diabetes with a mildly elevated hemoglobin A1c. Has hypertension with some control on the lisinopril, though not perfect. He is taking statins for hypercholesterolemia. And was initially treated with imatinib. Only achieved a minor cytogenetic response after 12 months, and therefore the treatment was changed to dasatinib 100 mg daily.
So he did achieve a complete cytogenetic response, but never a major molecular response. And then eventually he has an increase in the transcript levels. You do a mutation analysis, and you find that the patient has a mutation T315I. So at this point, what would you recommend for the patient? To increase the dose of dasatinib? Change to imatinib 600 mg daily? Change to nivolumab 400 mg twice daily? Change to bosutinib 500 mg daily? Change to ponatinib 30 mg daily? Change to asciminib 200 mg twice daily? Or a stem cell transplant?
Well, in my opinion, the optimal therapy for this patient is asciminib 200 mg twice daily. We know that imatinib, dasatinib, nilotinib, or bosutinib have no clinical benefit against the T315I so those are not good options. Ponatinib does have activity against T315I, but it is very it is very dose dependent. Clearly, those patients are the ones that mostly need a dose of 45 mg daily to achieve a response. The probability of response drops significantly when you use 30 mg daily. Now, this patient has comorbidities, so using 45 mg daily could be a problem. So the ponatinib could be a good choice. I think that asciminib with a better toxicity profile, it provides a greater probability of benefit. Now, transplant is definitely a consideration. But again, with the age and the comorbidities of the patient, I would at least give it a trial with asciminib to see if we can get a good response. And we know that about 60% of patients can get a major molecular response, so I think it is the best possibility for this patient.
Let's review another patient now. A 35-year-old female patient is diagnosed with CML. Newly diagnosed. Comes to you. You do a confirmation with a bone marrow. She is in chronic phase, has no additional chromosomal abnormalities. The Sokal risk is low.
Now, she tells you she's interested in eventually having a family, and therefore for her, the possibility of stopping therapy at some point, and the sooner the better, is very important. So with that in mind, what is your recommendation among the drugs that are approved as initial therapy for CML? You want to start on imatinib? Dasatinib? Nilotinib? Bosutinib? Or asciminib?
Well, all of these options are good, no question. Now, certainly we know that second-generation TKIs give a better probability of treatment-free remission than imatinib. However, based on the data from the ASC4FIRST study, we know that asciminib gives early responses, by 3 months and early molecular responses by 48 weeks, the major molecular response higher than all of the other tyrosine kinase inhibitors that are approved for frontline therapy. So with that in mind, I think it is likely that asciminib will give this patient the better probability of having a treatment discontinuation, and perhaps earlier than any of the other drugs. So that would be my first choice for this patient.
Thank you for your attention.
Announcer:
You have been listening to CME on ReachMD. This activity is provided by AXIS Medical Education.
To receive your free CME credit, or to download this activity, go to ReachMD.com/CME. Thank you for listening.
Ready to Claim Your Credits?
You have attempts to pass this post-test. Take your time and review carefully before submitting.
Good luck!
Overview
Disclosure of Relevant Financial Relationships
AXIS Medical Education requires faculty, instructors, authors, planners, directors, managers, peer reviewers, and other individuals who are in a position to control the content of this activity to disclose all personal financial relationships they may have in the past 24 months with ineligible companies. An ineligible entity is any organization whose primary business is producing, marketing, selling, re-selling, or distributing healthcare products used by or on patients. All relevant financial relationships are identified and mitigated prior to initiation of the planning phase for an activity.
AXIS has mitigated and disclosed to learners all relevant financial relationships disclosed by staff, planners, faculty/authors, peer reviewers, or others in control of content for this activity. Disclosure of a relationship is not intended to suggest or condone bias in any presentation but is made to provide participants with information that might be of potential importance to their evaluation of a presentation or activity. Disclosure information for faculty, authors, course directors, planners, peer reviewers, and/or relevant staff is provided with this activity. The faculty reported the following relevant financial relationships or relationships they have with ineligible companies of any amount during the past 24 months:
Jorge Cortes, MD reported a financial interest/relationship or affiliation in the form of
Consultant: Ascentage, BioPath Holdings, Nerviano, Novartis Pharmaceuticals, Pfizer, Inc., Sun Pharma, Takeda Oncology, Tern Pharma.
Research: Ascentage, CytoAgents, Kuro, Novartis Pharmaceuticals, Sun Pharma.
The directors, planners, managers, peer reviewers, and relevant staff reported the following financial relationships they have with any ineligible company of any amount during the past 24 months: Linda Gracie-King, MS; Bing-E Xu, PhD; Marilyn L. Haas-Haseman, PhD, RN, CNS, ANP-BC; Melissa Duffy, PA-C; and Adrienne N. Nedved, PharmD, MPA, BCOP hereby state that they do not have any financial relationships or relationships with any ineligible company of in any amount during the past 24 months. Robert Mocharnuk, MD, reports a financial interest/relationship or affiliation in the form of Common stock: Merck during the past 24 months.Learning Objectives
After participating in this educational activity, participants should be better able to:
- Apply various TKI treatment options in the frontline setting based on updated guidelines, emerging trial data, and changes in real-world evidence when developing personalized treatment approaches for CML patients
- Integrate BCR-ABL transcript and mutational testing and other team-based strategies to inform TKI selection and achieve EMR, MMR, and DMR in patients with CML to potentially lead to treatment-free remission
- Plan effective team-based strategies for mitigation and management of potential AEs and drug resistance resulting from CML treatment, while optimizing adherence
Target Audience
This activity is designed to meet the educational needs of hematologists/oncologists and pathologists as well as all other physicians, physician assistants, nurse practitioners, nurses, pharmacists, and other members of the interprofessional team who are involved in the management of patients with Ph+CML-CP.
Accreditation and Credit Designation Statements
In support of improving patient care, AXIS Medical Education is jointly accredited by the Accreditation Council for Continuing Medical Education (ACCME), the Accreditation Council for Pharmacy Education (ACPE), and the American Nurses Credentialing Center (ANCC), to provide continuing education for the healthcare team.
This activity was planned by and for the healthcare team, and learners will receive 0.25 Interprofessional Continuing Education (IPCE) credit for learning and change.
AXIS Medical Education designates this enduring material for 0.25 AMA PRA Category 1 Credit(s)™.
Physicians should claim only the credit commensurate with the extent of their participation in the activity.
AXIS Medical Education has been authorized by the American Academy of PAs (AAPA) to award AAPA Category 1 CME credit for activities planned in accordance with AAPA CME Criteria. This activity is designated for 0.25 AAPA Category 1 CME credits. Approval is valid until 01/14/26. PAs should only claim credit commensurate with the extent of their participation.
This knowledge-based activity is approved for 0.25 contact hours of continuing pharmacy education JA4008106-0000-25-001-H01-P.
AXIS Medical Education designates this continuing nursing education activity for 0.25 contact hours. Learners are advised that accredited status does not imply endorsement by the provider or ANCC of any commercial products displayed in conjunction with an activity.
This continuing medical laboratory education activity is recognized by the American Society for Clinical Pathology as meeting the criteria for 0.25 CMLE credit. ASCP CMLE credits are acceptable to meet the continuing education requirement for the ASCP Board of Registry Certification Maintenance Program.Provider(s)/Educational Partner(s)

Commercial Support
This activity is supported by an independent educational grant from Novartis.
Disclaimer
Disclosure of Unlabeled Use
This educational activity may contain discussion of agents that are not approved for use by the FDA and/or investigational (“off-label”) uses of agents that are approved by the FDA. The planners of this activity do not recommend the use of any agent outside of its labeled indications. The opinions expressed in the educational activity are those of the faculty and do not necessarily represent the views of the planners. Please refer to the official prescribing information for each agent for information on its approved indications, contraindications, warnings, and other, related information.
Disclaimer
Participants have an implied responsibility to use the newly acquired information to enhance patient outcomes and their own professional development. The information presented in this activity is not meant to serve as a guideline for patient management. Any procedures, medications, or other courses of diagnosis or treatment discussed or suggested in this activity should not be used by clinicians without evaluation of their patient’s conditions and possible contraindications and/or dangers in use, review of any applicable manufacturer’s product information, and comparison with recommendations of other authorities.
There is no fee for this educational activity.System Requirements
- Supported Browsers (2 most recent versions):
- Google Chrome for Windows, Mac OS, iOS, and Android
- Apple Safari for Mac OS and iOS
- Mozilla Firefox for Windows, Mac OS, iOS, and Android
- Microsoft Edge for Windows
- Recommended Internet Speed: 5Mbps+
Publication Dates
Release Date:
Expiration Date:
Overview
Although the first-generation tyrosine kinase inhibitors (TKIs) revolutionized the treatment of Ph+ CML-CP, the rate of resistance to these agents is high, and many patients require further treatment with second- and third-line therapy. The development of newer drugs with unique mechanisms that can overcome these resistance phenotypes offers new treatment strategies that can maintain response rates. This activity reviews the current treatment options for newly diagnosed disease and the importance of integrating patient preference when planning therapeutic regimens.
Disclosure of Relevant Financial Relationships
AXIS Medical Education requires faculty, instructors, authors, planners, directors, managers, peer reviewers, and other individuals who are in a position to control the content of this activity to disclose all personal financial relationships they may have in the past 24 months with ineligible companies. An ineligible entity is any organization whose primary business is producing, marketing, selling, re-selling, or distributing healthcare products used by or on patients. All relevant financial relationships are identified and mitigated prior to initiation of the planning phase for an activity.
AXIS has mitigated and disclosed to learners all relevant financial relationships disclosed by staff, planners, faculty/authors, peer reviewers, or others in control of content for this activity. Disclosure of a relationship is not intended to suggest or condone bias in any presentation but is made to provide participants with information that might be of potential importance to their evaluation of a presentation or activity. Disclosure information for faculty, authors, course directors, planners, peer reviewers, and/or relevant staff is provided with this activity. The faculty reported the following relevant financial relationships or relationships they have with ineligible companies of any amount during the past 24 months:
Jorge Cortes, MD reported a financial interest/relationship or affiliation in the form of
Consultant: Ascentage, BioPath Holdings, Nerviano, Novartis Pharmaceuticals, Pfizer, Inc., Sun Pharma, Takeda Oncology, Tern Pharma.
Research: Ascentage, CytoAgents, Kuro, Novartis Pharmaceuticals, Sun Pharma.
The directors, planners, managers, peer reviewers, and relevant staff reported the following financial relationships they have with any ineligible company of any amount during the past 24 months: Linda Gracie-King, MS; Bing-E Xu, PhD; Marilyn L. Haas-Haseman, PhD, RN, CNS, ANP-BC; Melissa Duffy, PA-C; and Adrienne N. Nedved, PharmD, MPA, BCOP hereby state that they do not have any financial relationships or relationships with any ineligible company of in any amount during the past 24 months. Robert Mocharnuk, MD, reports a financial interest/relationship or affiliation in the form of Common stock: Merck during the past 24 months.Learning Objectives
After participating in this educational activity, participants should be better able to:
- Apply various TKI treatment options in the frontline setting based on updated guidelines, emerging trial data, and changes in real-world evidence when developing personalized treatment approaches for CML patients
- Integrate BCR-ABL transcript and mutational testing and other team-based strategies to inform TKI selection and achieve EMR, MMR, and DMR in patients with CML to potentially lead to treatment-free remission
- Plan effective team-based strategies for mitigation and management of potential AEs and drug resistance resulting from CML treatment, while optimizing adherence
Target Audience
This activity is designed to meet the educational needs of hematologists/oncologists and pathologists as well as all other physicians, physician assistants, nurse practitioners, nurses, pharmacists, and other members of the interprofessional team who are involved in the management of patients with Ph+CML-CP.
Accreditation and Credit Designation Statements
In support of improving patient care, AXIS Medical Education is jointly accredited by the Accreditation Council for Continuing Medical Education (ACCME), the Accreditation Council for Pharmacy Education (ACPE), and the American Nurses Credentialing Center (ANCC), to provide continuing education for the healthcare team.
This activity was planned by and for the healthcare team, and learners will receive 0.25 Interprofessional Continuing Education (IPCE) credit for learning and change.
AXIS Medical Education designates this enduring material for 0.25 AMA PRA Category 1 Credit(s)™.
Physicians should claim only the credit commensurate with the extent of their participation in the activity.
AXIS Medical Education has been authorized by the American Academy of PAs (AAPA) to award AAPA Category 1 CME credit for activities planned in accordance with AAPA CME Criteria. This activity is designated for 0.25 AAPA Category 1 CME credits. Approval is valid until 01/14/26. PAs should only claim credit commensurate with the extent of their participation.
This knowledge-based activity is approved for 0.25 contact hours of continuing pharmacy education JA4008106-0000-25-001-H01-P.
AXIS Medical Education designates this continuing nursing education activity for 0.25 contact hours. Learners are advised that accredited status does not imply endorsement by the provider or ANCC of any commercial products displayed in conjunction with an activity.
This continuing medical laboratory education activity is recognized by the American Society for Clinical Pathology as meeting the criteria for 0.25 CMLE credit. ASCP CMLE credits are acceptable to meet the continuing education requirement for the ASCP Board of Registry Certification Maintenance Program.Provider(s)/Educational Partner(s)

Commercial Support
This activity is supported by an independent educational grant from Novartis.
Disclaimer
Disclosure of Unlabeled Use
This educational activity may contain discussion of agents that are not approved for use by the FDA and/or investigational (“off-label”) uses of agents that are approved by the FDA. The planners of this activity do not recommend the use of any agent outside of its labeled indications. The opinions expressed in the educational activity are those of the faculty and do not necessarily represent the views of the planners. Please refer to the official prescribing information for each agent for information on its approved indications, contraindications, warnings, and other, related information.
Disclaimer
Participants have an implied responsibility to use the newly acquired information to enhance patient outcomes and their own professional development. The information presented in this activity is not meant to serve as a guideline for patient management. Any procedures, medications, or other courses of diagnosis or treatment discussed or suggested in this activity should not be used by clinicians without evaluation of their patient’s conditions and possible contraindications and/or dangers in use, review of any applicable manufacturer’s product information, and comparison with recommendations of other authorities.
There is no fee for this educational activity.System Requirements
- Supported Browsers (2 most recent versions):
- Google Chrome for Windows, Mac OS, iOS, and Android
- Apple Safari for Mac OS and iOS
- Mozilla Firefox for Windows, Mac OS, iOS, and Android
- Microsoft Edge for Windows
- Recommended Internet Speed: 5Mbps+
Publication Dates
Release Date:
Expiration Date:
Title
Share on ReachMD
CloseProgram Chapters
Segment Chapters
Playlist:
Recommended
We’re glad to see you’re enjoying ReachMD…
but how about a more personalized experience?


